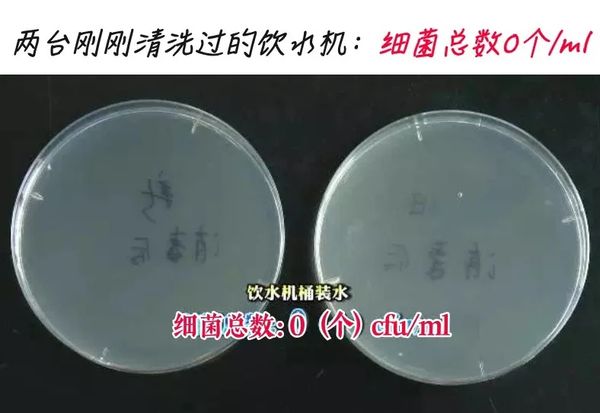

每天要喝够8杯水?喝水这事,很多人都搞错了
来源:新华网
今天你喝够8杯水了吗?
一直以来,“每天喝够8杯水”似乎是很多人统一的认知。还有些说法则认为“千滚水、隔夜水不能喝”。那么对于普通人来说,每天喝多少水才合适?怎么喝水才正确呢?
今天就让我们来聊聊关于喝水的那些事儿。

1
看完这5个喝水常识
感觉我现在强得可怕
①这3种水哪种好:矿泉水、蒸馏水、自来水?
都好,但白开水最省钱。
有说法称,矿泉水、天然矿泉水符合“国标 GB8537”,含有丰富的矿物质,水源是天然、优质水源,更值得推荐。但其实,矿泉水和其他种类的饮用水相比,除了有更多的矿物质成分,其他方面并无太大区别。
矿泉水、蒸馏水、这些水名头多,主要是工艺不同,微量元素含量不同。但想补微量元素,不如吃蔬菜、水果、肉等其他食物。
喝水的主要目的是补水,从这点来看,这些水没区别,选哪种都一样。
②每天都要喝够8杯水吗?
8杯水只是一个理论上的概念。
成年人每天平均需水量在2500毫升以上,其中约1500~2000毫升来源于直接饮水,余下的则从食物中摄取,在高温和干燥的特殊环境下人体需水量会适当增加。
当夏天气温比较高,户外活动时可以适当增加饮水量。尤其要注意:
别等渴了才喝:感到口渴时,身体其实已经处于一个比较缺水的状态;
建议定时喝:大概每隔1个小时左右,喝100到150毫升的水;
注意水温:水过冷、过热都会刺激胃黏膜。不要喝5摄氏度以下的饮料,喝10摄氏度左右的凉开水最好。
运动后应小口喝水:小口喝水既能减少对胃肠道的刺激,又能保持人的体液平衡。

③啥时候喝水最健康?
早晨醒来之后喝。
通常,人体每天夜间呼吸和皮肤蒸发要损失掉300~400ml水,早上血液处于比较黏稠的状态。
早上醒来先喝杯水,不仅可以补充因身体代谢失去的水分、洗涤已排空的肠胃,还能降低血黏稠度,预防心脑血管疾病的发生。
空腹时饮水最有效,水会直接从消化道中被身体吸收。多喝水也能消汗、促进小便,除了能降低体温外,还能排出血液中的有毒物质。
④口渴时,能喝啤酒、咖啡解渴吗?
啤酒和咖啡,都有利尿作用。
用这种方式解渴,反而会导致身体排出更多的水分,得不偿失。
⑤喝桶装水要注意啥?
注意这2点就行——
最好选11L小桶装的饮用水(因为桶装水易二次污染),开封后尽快饮用,3天后最好经煮沸后再饮用。
饮水机定时清洁,有条件的建议每周清洗一次,最少每月要清洗一次。也别自己费劲鼓捣,最好请具有相关资质的公司或专业人员清洗。

图源:央视新闻
2
关于喝水的6大谣言
1、“千滚水”喝了会致癌?
不能抛开剂量谈毒性。
多次烧开的自来水中亚硝酸盐含量的确会增加,但水里的亚硝酸盐含量本身就很低,远低于国家标准。
与其担心“千滚水”里的那一丁点亚硝酸盐,还不如少吃一些酸豆角等含亚硝酸盐的食品。
2、常喝硬水会得肾结石?
水的软硬程度,指的是水中钙离子和镁离子的含量高低。目前没有充足证据表明水垢会导致肾结石或其他健康问题。
真正容易引起结石病和泌尿系统疾病的,是喝不够水。
3、喝碱性水会更健康?
普通人没有必要专门饮用弱碱性水,水的pH值与人体健康的关系目前并没有得到证明。

4、边吃饭边喝水会消化不良?
其实喝水不会影响胃的消化功能,边吃饭边喝水只要不是大量喝水,对普通人来说没有什么问题。餐前半小时喝水还有助于控制体重。
5、水喝多了会浮肿?
水:这锅我不背。
浮肿的原因并不是摄取水分过多,可能是心脏、肾脏、肝脏等器官出了问题的“警报”。
6、水喝得越多越好?
当然了,说了这么多,并不是让大家就去拼命灌水。
在机体不缺水的情况下,一次性饮用大量的水,超出生理需求,反而会造成反效果。
摄入过量的水,细胞中水分含量上升,最坏的结果会引起“水中毒”,危害生命。
但也不用担心,只要不是一次性灌下好几升水,健康的年轻人,一般都摊不上这事儿。
评论列表 共有 0 条评论
最新导读

热门文章




发表评论 取消回复